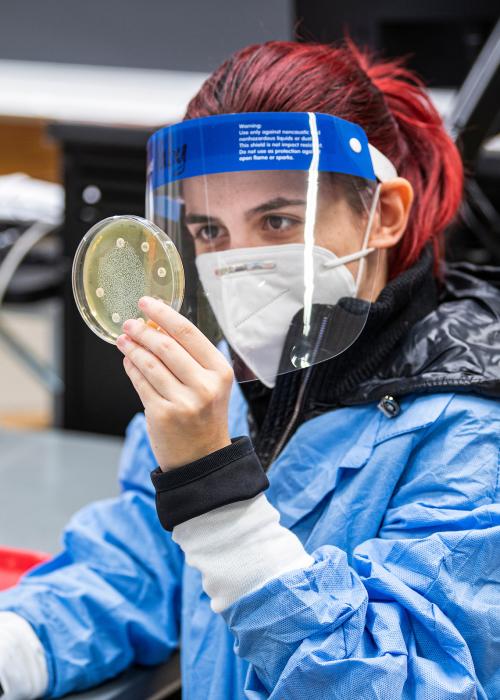
Student in a lab

Department of Biological Sciences

The study of life—it’s only natural.
Through the Department of Biological Sciences, you’ll be immersed in the life sciences from your first day—and faculty will ensure that you receive the education you need to pursue your dream career.
About The Department


Programs
Nurturing the next generation of biologists. It’s what we do.
Health. Environment. Biotechnology. No matter your direction, we have a program to challenge you to go beyond what you thought possible.


$89,910
Median annual salary of a biological scientist
5
Unique Degree Programs
Faculty
It takes dedicated faculty to guide you toward success.
You’ll learn from top researchers who are experts in their field as you turn your passion for all things biology into your career.